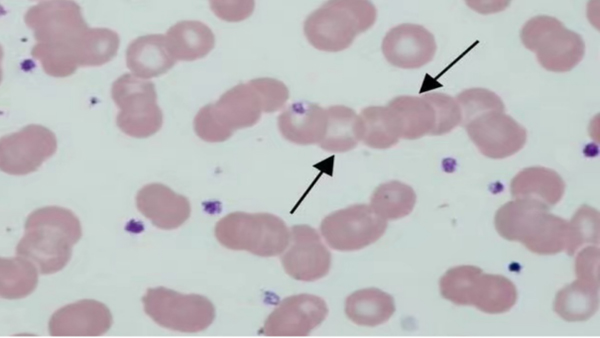
640 (13)_1.jpg

科普文章
【垂医科普】带您了解血沉
临床工作中血沉是较为常用的检测项目。那么血沉异常严重吗?
首先我们来了解一下什么是血沉。
红细胞沉降率(ESR)即血沉,是指红细胞在一定条件下的下降速度。血流中的红细胞因细胞膜表面的粘液具有负电荷等因素而相互排斥,使细胞间距离约为25nm,彼此分散悬浮而下沉缓慢。红细胞沉降速度受多种因素影响,其中最基本的因素是红细胞缗钱状的形成。
影响形成缗钱状的因素
1.血浆中各种蛋白的比例:白蛋白、球蛋白与纤维蛋白原、胆固醇、甘油三酯有促进作用;卵磷脂有抑制作用;
2.红细胞数量和形状:红细胞减少时ESR加快;红细胞增多时ESR减慢;红细胞直径越大,ESR愈快;球形红细胞不易形成缗钱状,ESR减慢。

血沉正常值参考范围:男性0-10mm/h;女性0-20mm/h;儿童0-10mm/h

血沉异常见于哪些疾病
NO.1 血沉增快
(一)血沉生理性增快见于:
<12岁的儿童;
>60岁的老年人;
妇女月经期间
(二)血沉病理性增快见于:
1.感染性疾病:细菌性感染如肺炎、胃肠炎,血中急性反应期物质迅速增多,如α2巨球蛋白、C-反应蛋白、α1抗胰蛋白酶、纤维蛋白原等易引起红细胞缗钱状聚集,一般于炎症发生后2~3天即可见血沉增快;风湿热、结核病:纤维蛋白原及Ig含量↑,ESR↑;临床上常应用ESR观察结核病及风湿热有无活动以及动态变化:疾病活动期ESR加快,病变渐趋静止时ESR亦逐渐正常;
2.恶性肿瘤:增长迅速的恶性肿瘤血沉增快,可能与肿瘤细胞分泌糖蛋白(属球蛋白)、肿瘤组织坏死,继发感染贫血等因素有关;良性肿瘤血沉多正常;
3.组织损伤或坏死时,如心肌梗死、脑梗死、手术创伤等;较大组织损伤或手术创伤,或脏器梗死后造成的组织坏死均可引起血沉加快。故可借血沉结果鉴别功能性与器质性疾病,如急性心梗时血沉增快,而心绞痛则无改变;
4.自身免疫性疾病:免疫系统对自身抗原产生持续和持久的免疫反应,导致自身组织细胞损伤或功能异常。如干燥综合征、系统性红斑狼疮、类风湿性关节炎等疾病活动性期患者血沉加快;
5.各种原因导致血浆球蛋白相对或绝对增高:慢性肾炎,肝硬化,多发性骨髓瘤,巨球蛋白血症,淋巴瘤,系统性红斑狼疮,亚急性感染性心内膜炎,黑热病等;
6.各种慢性刺激;
7.其他:部分贫血患者,当Hb<90g/L,ESR轻度增高,动脉粥样硬化、糖尿病、肾病综合症、粘液水肿等患者,血中胆固醇增高,血沉亦见增快。

NO.2 血沉减慢
临床意义较小;严重贫血、球形红细胞增多症、纤维蛋白含量重度缺乏,血沉可减慢。
文章仅用于公益科普及学术交流,部分资料和图片来源于网络,如有侵权,请联系删除。
- 标签:








京公网安备11010502033717号